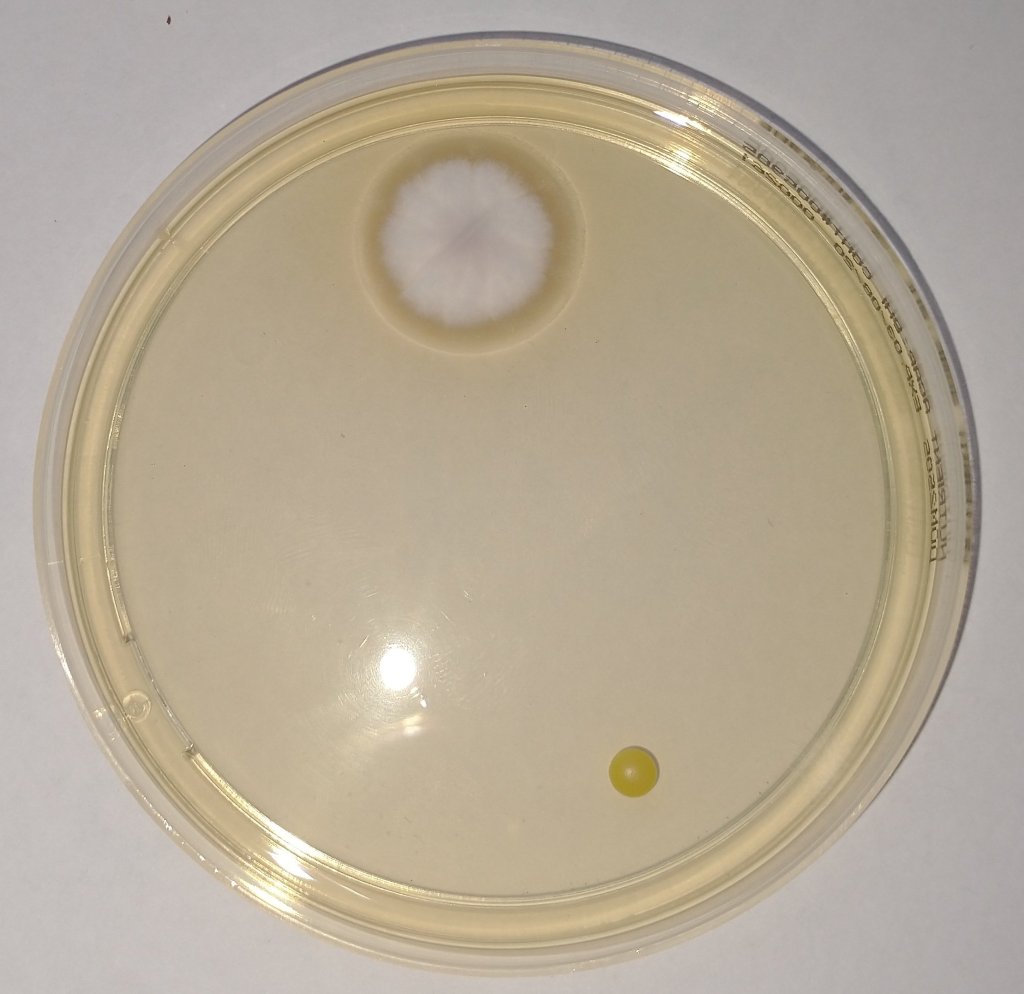
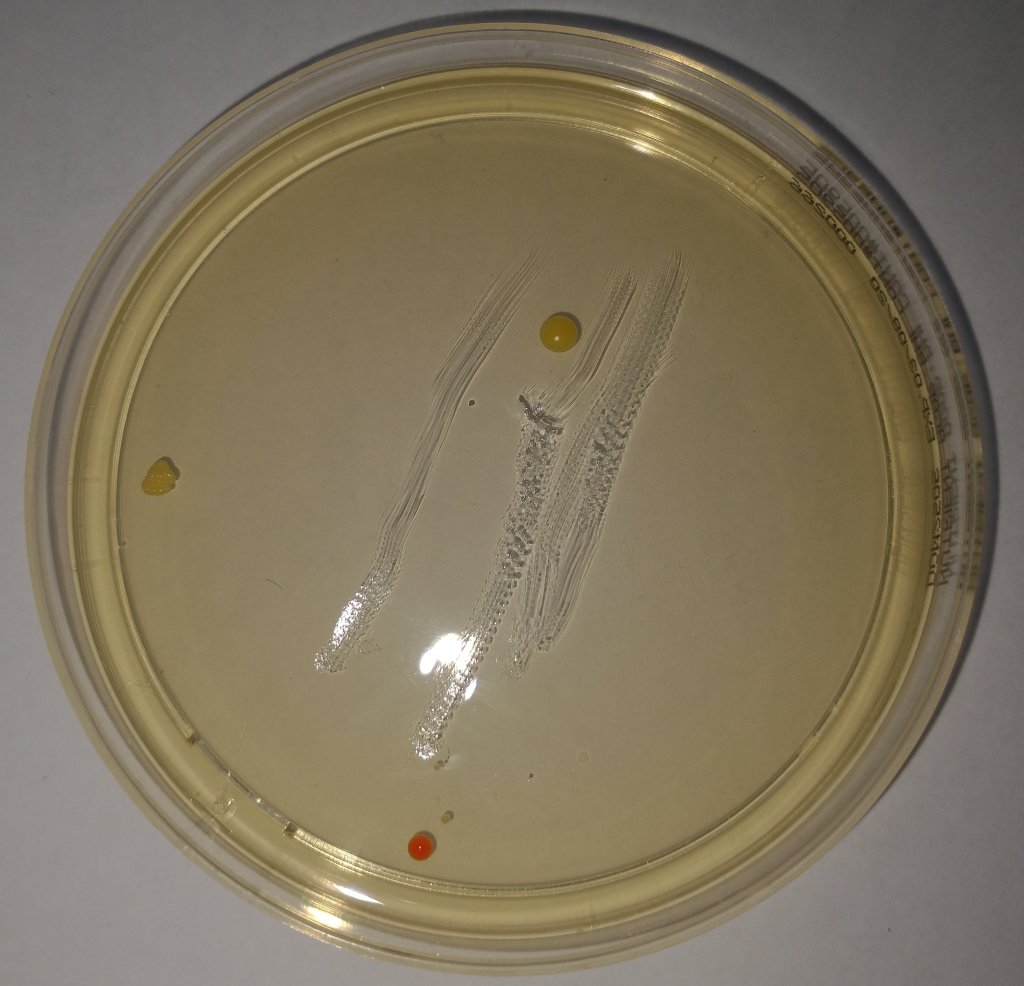
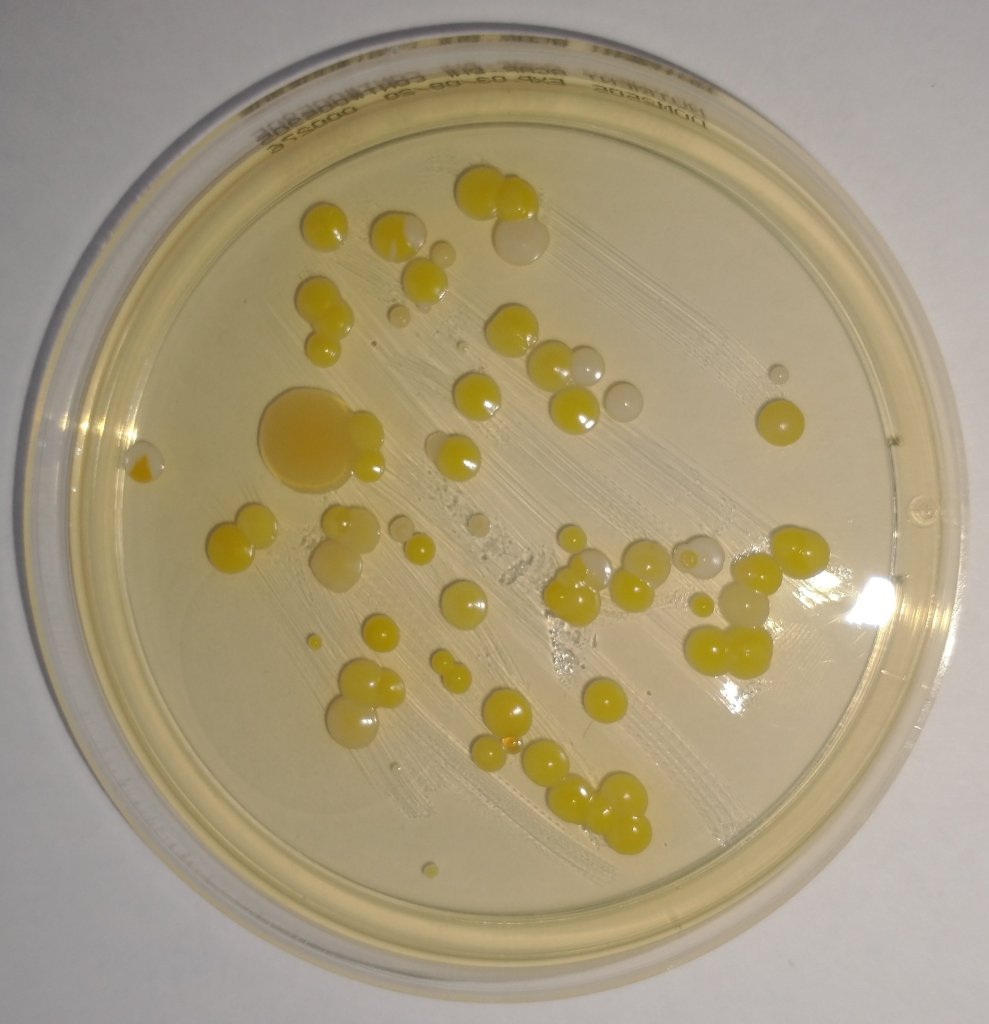
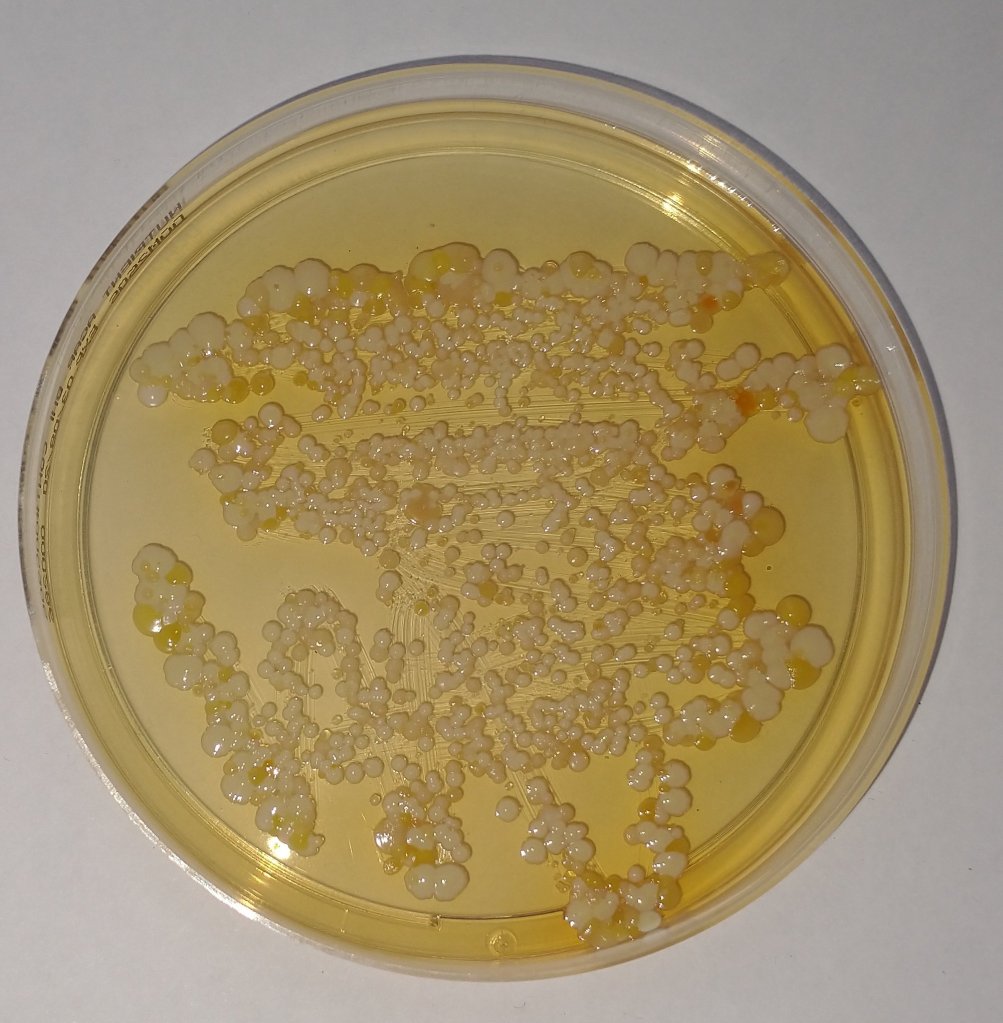
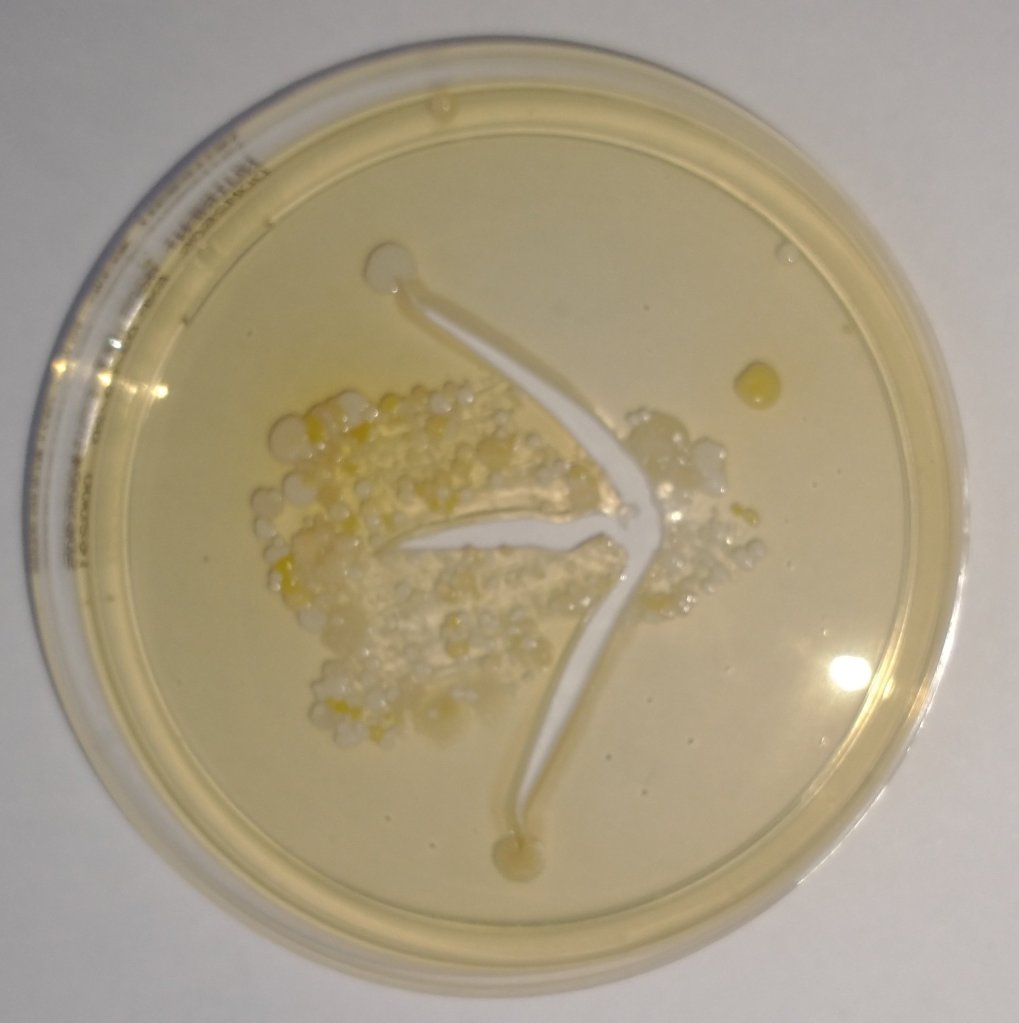
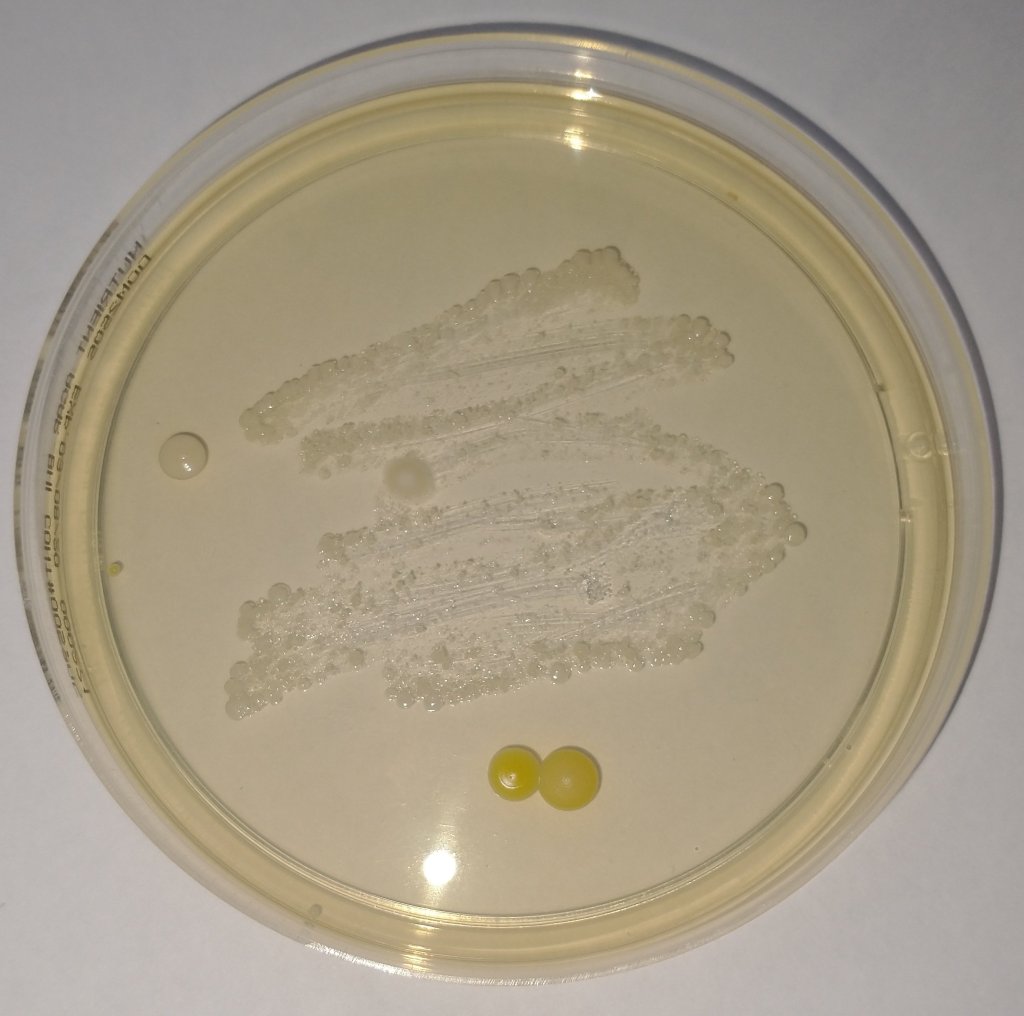

Hypothesis
The intention for this experiment was to take bacteria samples on different objects commonly found inside a household and see which surfaces has the most bacteria. these surfaces were tested:
- toilet seat
- mobile phone
- kitchen counter
- human feet
- inside of human mouth
This experiment will also prove that agar we selected could grow bacteria and cotton buds are sterile enough to collected samples without biasing the result.
So the 3 outcomes are:
- Confirm the agar can grow bacteria
- Confirm the cotton buds do not significantly contaminate the samples
- Measure the bacteria from the 5 samples above
Materials
- Agar plates
- Cotton buds
- Warm dark place to store agar plates
Method
- Open agar plates carefully not to contaminate the agar.
- Take a sample of your chosen surfaces using a cotton bud.
- Rub cotton bud onto agar.
- Put lids back on agar plates
- Put in a dry dark space and check daily
- Leave for about 5 days
Results
The agar worked and grew bacteria.
The control sample was reasonably clean:
Cotton buds are reasonably sterile:
The samples collected looked as follows by day 5:
Counter 
Phone
Toilet seat
Foot
Mouth
4 visibly different types of bacteria were growing on the samples:
- White spots mostly on samples with human skin contact
- Yellow spots mostly on hard surface samples
- Red spot on the cotton bud sample
- White fluffy growth on the control sample
Conclusion
From this, the following conclusions were drawn:
- The agar can grow bacteria
- Cotton buds are sterile enough for samples
- Toilet seat had the most bacteria with the foot sample second
- Kitchen counter and phone was similar
- Mouth was reasonably clean by comparison
Further Experiments
- Bacteria in breath
- Bacteria growth when the lid is left off (ambient bacteria)
- The inside of the toilet bowel compared to the seat
- Keyboard sample vs kitchen counter
- Bacteria in soil
- Bacteria on soap
Hey interesting, maybe you should check your hand after a wash then again an hour later.
LikeLike